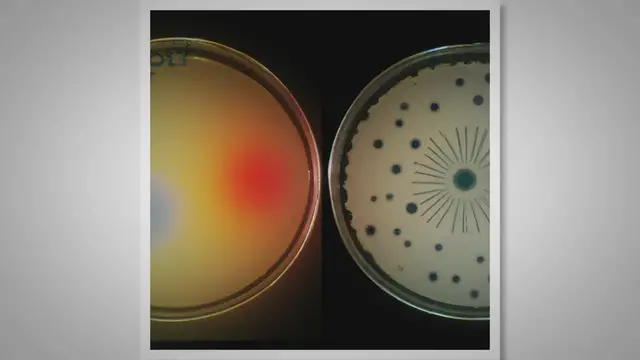
Video thumbnail for Difference Between Positive and Negative Control

Difference Between Positive and Negative Control
May 15, 2023
In this educational video, we explore the fundamental concept of the "Difference Between Positive and Negative Control" in scientific experiments. Whether you're a student or a curious mind, understanding these controls is crucial for conducting accurate and meaningful research. positive control, negative control, scientific experiments, baseline, validation, accurate research, meaningful research, biology, chemistry, medicine, practical examples
Show More Show Less 